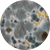
BMZ75

Izvedbeni plan nastave Sveučilišnog diplomskog studija Biologija; smjer Znanstveni (DZSB)
I. GODINA STUDIJA
akademska godina 2025./2026. Izmjene 07.10.2025.
I. Zimski semestar
bold = nositelj predmeta
Italic = vanjski suradnik
* = nastava moguća i na engleskom jeziku

Izv. prof. dr. sc. Senka Blažetić
Doc. dr. sc. Ana Vuković Popović

Prof. dr. sc. Davorka Hackenberger Kutuzović
Prof. dr. sc. Branimir Hackenberger Kutuzović

Izv. prof. dr. sc. Vesna Peršić

Izv. prof. dr. sc. Zorana Katanić

Prof. dr. sc. Branimir Hackenberger Kutuzović
Dr. sc. Tamara Đerđ, viši asistent

Izv. prof. dr. sc. Vesna Peršić
IZBORNI PREDMETI (6 ECTS-a)

Izv. prof. dr. sc. Zorana Katanić

Prof. dr. sc. Branimir Hackenberger Kutuzović
Izv. prof. dr. sc. Sandra Ečimović

Prof. dr. sc. Valentina Pavić

Izv.prof.dr.sc. Lidija Kalinić
Izv. prof. dr. sc. Selma Mlinarić
Doc. dr. sc. Martina Varga
Izv. prof. dr. sc. Vesna Peršić
Gabrijel Mirković, asistent
I. GODINA STUDIJA
akademska godina 2025./2026. Izmjene 07.10.2025.
II. Ljetni semestar
bold = nositelj predmeta
Italic = vanjski suradnik
* = nastava moguća i na engleskom jeziku

Izv. prof. dr. sc. Anita Galir
Izv. prof. dr. sc. Filip Stević
Fran Prašnikar, asistent

Prof. dr. sc. Ivna Štolfa Čamagajevac

Doc. dr. sc. Barbara Vlaičević
Doc. dr. sc. Mislav Kovačić
Ivana Turković Čakalić, stručni savjetnik

Prof. dr. sc. Melita Mihaljević
Izv. prof. dr. sc. Filip Stević
Izv. prof. dr. sc. Dubravka Špoljarić Maronić
Doc. dr. sc. Barbara Vlaičević
Ivana Turković Čakalić, stručni savjetnik

Prof. dr. sc. Branimir Hackenberger Kutuzović
Prof. dr. sc. Davorka Hackenberger Kutuzović
Izv. prof. dr. sc. Sandra Ečimović

IZBORNI PREDMETI (6 ECTS-a)

Prof. dr. sc. Enrih Merdić
Izv. prof. dr. sc. Mirta Sudarić Bogojević
Doc. dr. sc. Goran Vignjević

Doc. dr. sc. Jasenka Antunović Dunić
Izv. prof. dr. sc. Selma Mlinarić
Izv. prof. dr. sc. Lidija Kalinić

Prof. dr. sc. Branimir Hackenberger Kutuzović



Gabrijel Mirković, asistent
Tihana Miloloža, stručni suradnik


Prof. dr. sc. Davorka Hackenberger Kutuzović

